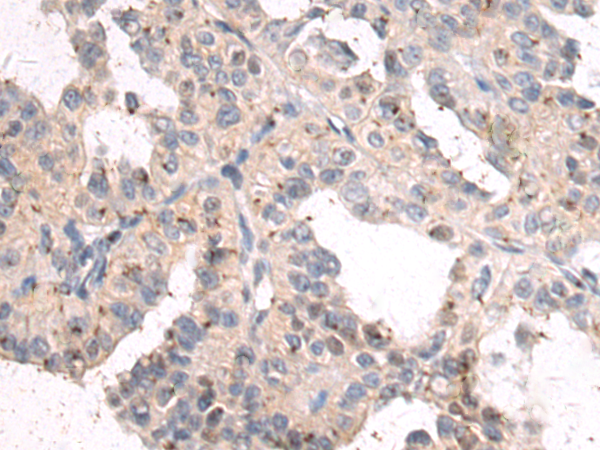
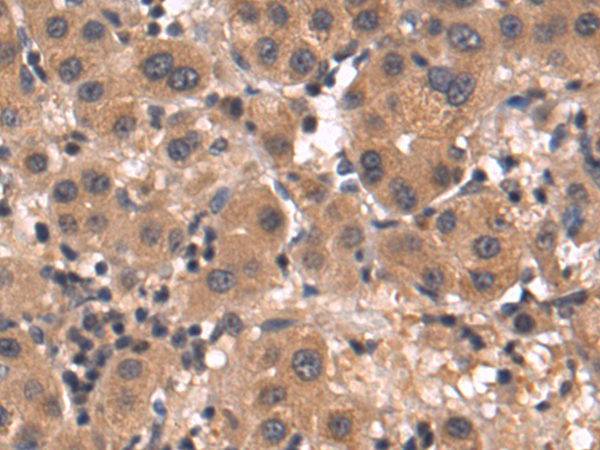

-
分类: 科研抗体货号: P10604别名: MCS; MOS; HMCS应用: IHC反应种属: Human
-
分类: 科研抗体货号: P10621别名: POR1应用: IHC反应种属: Human, Mouse, Rat
-
分类: 科研抗体货号: P10641别名: ACEH应用: IHC反应种属: Human, Mouse, Rat
-
分类: 科研抗体货号: P10603别名: INT7; C1orf73应用: WB反应种属: Human, Mouse
-
分类: 科研抗体货号: P10620别名: SDS; SWDS; CGI-97应用: WB,IHC反应种属: Human, Mouse, Rat
-
分类: 科研抗体货号: P10639别名: E3B1; ABI-1; ABLBP4; NAP1BP; SSH3BP; SSH3BP1应用: WB,IHC反应种属: Human, Mouse, Rat
-
分类: 科研抗体货号: P10602别名: FAM115A应用: IHC反应种属: Human, Mouse
-
分类: 科研抗体货号: P10619别名:应用: IHC反应种属: Human, Mouse
-
分类: 科研抗体货号: P10636别名: PI, A1A, AAT, PI1, A1AT, PRO2275, alpha1AT应用: WB,IHC反应种属: Human
-
分类: 科研抗体货号: P10617别名: LXRA; LXR-a; RLD-1应用: WB反应种属: Human, Mouse

鄂公网安备42018502007531号
鄂公网安备42018502007531号

